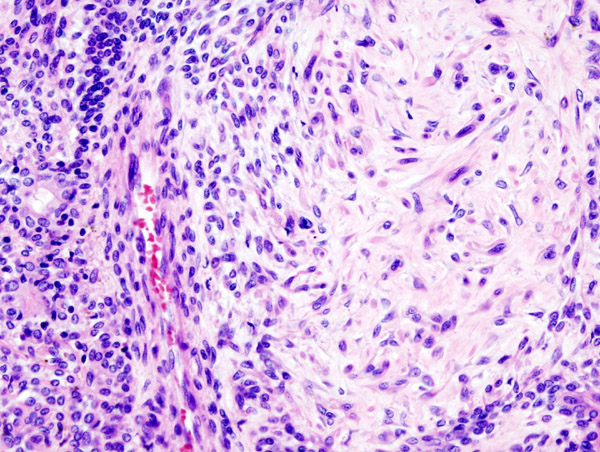
Pleomorphic Adenoma
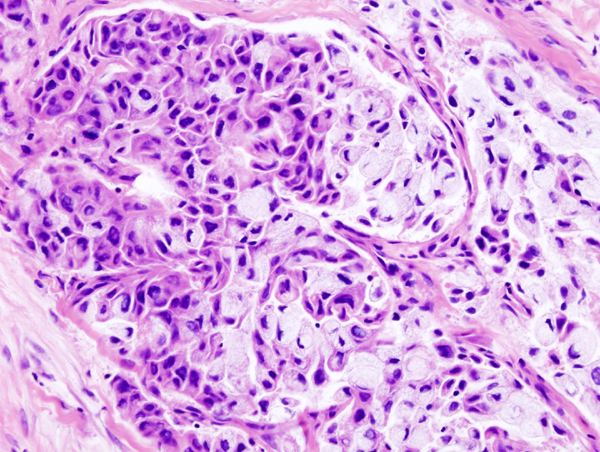
Mucoepidermoid Carcinoma
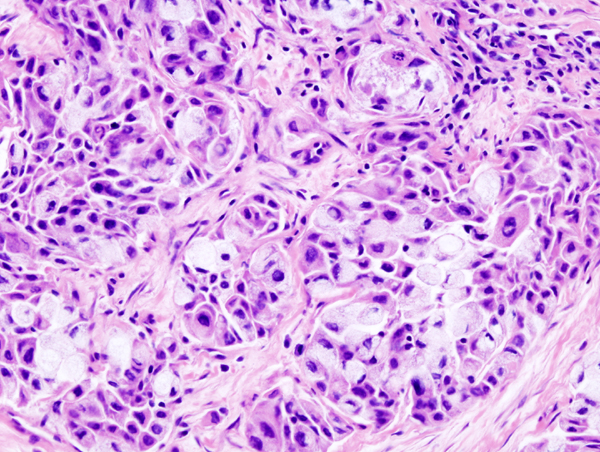
Mucoepidermoid Carcinoma

Salivary Gland Pathology Video
Salivary Gland Pathology
Saliva is produced by exocrine salivary glands, which are found inside the mouth.
There are three pairs of salivary glands, one pair in each of the tongue, lips, and cheeks beneath the skin.
Each gland consists of a duct that transports saliva from the gland’s primary formation site to the duct’s opening.
Just behind the upper front teeth, the duct enters the mouth’s floor.
Whenever one is awake, a small amount of saliva always gathers in the mouth.
We refer to this as resting flow.
Additional saliva is released while speaking, chewing, swallowing, and yawning.
This is called stimulated flow.
The parotid glands produce most of the saliva produced in the body.
They account for around 60% of the salivary glands’ overall volume.
About 2.0 cm long and 0.5 cm wide, these are sizable glands.
They are located above the bottom lip, under the ear lobes, and on both sides of the jawbone.
Near the corner of the mouth, the parotid glands protrude into the cheek.
The submandibular glands, which are roughly 3.0 cm long and 1.0 cm wide, are smaller than the parotid glands.
They are located close to the mandible bone, deep inside the neck.
Their openings are situated at the jaw’s angle.
Less than 1 mm wide, the sublingual glands are very small.
They are located right underneath the tongue in the floor of the mouth.
Their entrances are concealed behind the tongue’s underside.
The oral mucosa is covered in small salivary glands.
The hard palate, buccal mucosa, gingiva, labial mucosa, and ventral surface of the tongue all contain the majority of the glands.
Numerous of these glands are located extremely close to lymphatics, nerves, and blood arteries.
Many of these glands have uncertain functions.
Salivary gland pathology include:
- Mumps
- Sialadenitis
- Pleomorphic adenoma
- Warthin tumor
- Mucoepidermoid carcinoma
Mumps
Mumps can become inflamed and enlarged.
Symptoms of mumps include:
- Pain
- Bilateral swelling
- Fever
- Headache
- Muscle aches
- Exhaustion
- Appetite loss
Symptoms of mumps usually appear 10 days after being exposed to the virus.
Rarely, the mumps can lead to life-threatening side effects such as:
- Brain infection
- Pancreatic inflammation
- Liver disease
- Testicular damage
- Sterility
- Deafness
Sialadenitis
Sialadenitis is due to salivary gland inflammation.
Sialadenitis is usually unilateral.
Most frequently caused by an obstructing stone (sialolithiasis) that leads to Staphylococcus aureus infection.
Pleomorphic Adenoma
Pleomorphic adenoma is a benign tumor made up of both epithelial and stromal tissue.
Pleomorphic adenoma is the most common salivary gland tumor.
Pleomorphic adenoma appears as a moving, painless mass that is constrained to the angle of the jaw.
Histologically pleomorphic adenomas have a myxoid component and a stromal component.
Pleomorphic adenoma is associated with the PLAG1 gene mutation.
Treatment of pleomorphic adenoma is surgical resection.
Small islands of tumor that extend through the tumor capsule frequently result in an incomplete resection.
There is a high recurrence rate for excised pleomorphic adenomas.
Rarely the benign pleomorphic adenomas may develop into their malignant counterparts carcinoma-ex pleomorphic.
Warthin Tumor
Warthin tumor is a benign cystic tumor with a stroma that resembles a lymph node and many lymphocytes.
Warthin tumor is also known as papillary cystadenoma lymphomatosum.
Warthin tumor is the second most common salivary gland tumor.
Warthin tumor occurs almost invariably in the parotid.
Mucoepidermoid Carcinoma
Mucoepidermoid carcinoma is a malignant tumor made up of squamous and mucin-producing cells.
Mucoepidermoid carcinoma is the most common malignant tumor of the salivary gland.
Mucoepidermoid carcinoma often occurs in the parotid.
The facial nerve is frequently compromised by mucoepidermoid carcinoma.